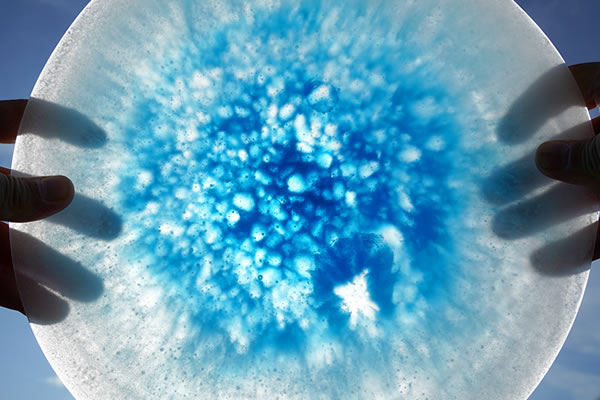

白白庵 企画 オンライン&ギャラリー開催 | PAKUPAKUAN presents Online & Gallery exhibition
~災い転じて福と為せ!~
Letʼs turn a misfortune into a blessing !
白白庵 企画 オンライン&ギャラリー開催
厄 除 ・ 迎 春 特 別 祈 念

PAKUPAKUAN presents :
Greeting the New Year special exhibition
"Great exhibition of lucky charm" 2021-2022
![]() |
【オンライン開催】
日時 2021年12月11日(土) 午前11時 ~ 26日(日)午後7時
会場 白白庵オンラインショップ 《PAKUPAKUAN.SHOP》 内特設ページ
【ON LINE viewing】
DATE & TIME : 2021.12.11 Sat. 11:00am. - 26 Sun. 7:00pm.
VENUE : Special issues page on 《PAKUPAKUAN.SHOP》
日程 2021年12月11日 (土)・12日 (日)・18日 (土)・19日 (日)・25日 (土)・26日 (日)《予約不要・入場無料》
*12月13日(月)、17日(金)、20日(月)・24日(金)はアポイント(事前予約)制でご来場いただけます。
訪問前日の営業時間内までにお問い合わせください(メール、電話、各種SNSからのメッセージにて)。
*マスク着用、入口でのアルコール消毒・検温必須とさせていただきます。
時間 午前11時~午後7時
会場 白白庵(1階エントランスギャラリー&茶室、2階サロン)
【GALLERY exhibition】
DATE : Saturday & Sunday during 2021.12.11 Sat. - 26 Sun. 《No appointment required, entrance free》
*Please contact us if you hope to visit gallery on Monday or Friday by mail, telephone, or message from any SNS.
*Closed on Tuesday, Wednesday and Thursday.
*Mask wearing, alcohol sterilization, the thermometry at the entrance are required.
TIME : 11:00am. to 7:00pm.
VENUE : PAKUPAKUAN (Entrance gallery at 1st floor & Tea room, salon at 2nd floor)
![]() |
| 前川多仁「鹿神様に願いをのせて」(部分) MAEKAWA Kazuhito “Wish on God of the deer” (part) |
【酒数奇者・佐々木達郎 の「俺の酒・俺の盃」ライブ配信】
無料配信
日時 12月11日(土) 午後5時~ (約1時間)
出演 佐々木 達郎 (酒数奇者 / 「酒器道楽」主宰)
田中 英一 (木工・漆器作家)
大下 邦弘 (ガラス造形作家)
*白白庵Facebookページから配信します。 https://www.facebook.com/pakupakuan
≫ 酒数奇者・佐々木達郎 の「俺の酒・俺の盃」過去のライブ配信動画
日本酒と作家の器の楽しみ方を提唱する「酒器道楽」主宰として、数多くの講座やイベント出演で白白庵でもお馴染みの佐々木達郎による新シリーズの第9回。
年内最後となる今回は、ゲスト作家2名を迎えての拡大版でお届けします!
毎回、器作家の個展に合わせてオンライン配信します(終了後もアーカイブで鑑賞可能)。
佐々木推奨の酒屋と提携し、季節のおすすめ日本酒二種を紹介しながら、作家の器の魅力と使い心地、お酒の味わい方などを楽しくレクチャー。
日本酒は酒屋のオンラインショップで、器作品は白白庵オンラインショップから、それぞれお求めいただけます。
【Talk live streaming by SASAKI Tatsuro (Man of well-cultivated tastes for sake) "My sake, my cups"】
viewing free
[Date] DEC 11 (Sat), 2021 [Time] 17:00~ (about 60min.)
[Talk live] SASAKI Tatsuro ("Man of well-cultivated tastes for sake" / The representative of "SHUKI DO-RAKU")
TANAKA Eiichi (Woodwork and lacquerware artist)
OSHITA Kunihiro (Glass artist)
*Stream on PAKUPAKUAN Facebook https://www.facebook.com/pakupakuan
≫ Talk live streaming by SASAKI Tatsuro, Past live streaming video.
![]() |
佐々木 達郎 SASAKI Tatsuro 酒数奇者(さけすきしゃ) 旨し酒、佳き肴、粋な器。その三位一体の悦楽を設える「酒器道楽」を主宰。蔵元でのイベントや懐石料理人とのユニット、古民家や料理屋での日本酒の会、茶人や花人、ギャラリーとのコラボレーションなど小粋な宴を多数開催。おとなの、乙な所作を通して、日本酒の魅力と器遣いの愉しみを伝えます。その真髄は酒席十二相に在り。日常は「いま粋」で「日々是逍遥」 |
![]() |
![]() |
| 星川あすか「一期一会」 HOSHIKAWA Asuka “Once-in-a-lifetime chance” | 金田花季「笑って、笑って!」 KANEDA Hanaki “Laugh, and laugh!” |
![]() |
| 伊豆野一政「吉兆豆皿(南天鯛鏡餅羽子板)」 IZUNO Kazumasa “Happy small dish set” |
|
年末恒例の大縁起物展も、昨年に続きコロナ禍を脱することのない中での開催となります。 いつの時代にも災厄はつきものだからこそ、厄除け・招福祈願の様々なアイテムが人々の手によって作られてきました。 来年こそは良い年になりますように。 その切なる願いをこめて、白白庵が推奨する作家たちが干支もの・縁起物を多数出品いたします。 皆様のご自宅で、ワークスペースで、集いの場で、縁起物たちを囲んで禍転じて福としましょう! |
| This year's annual "Great exhibition of lucky charm" will be held in the same way as last year under the COVID-19. Since disasters are inevitable in any age, people have been making various items to ward off evil spirits and pray for good fortune. We hope that next year will be a good one for you. With this earnest wish, PAKUPAKUAN's recommended artists will exhibit a variety of zodiac signsʼ artworks and lucky charms. Let's gather around these lucky charms in your home, workspace, or gathering place, and turn misfortune into good fortune! |
![]() |
| 栢野紀文「鏡餅」 KAYANO Kibun “Kagamimochi (Round rice cake for New Year's decoration)” |
![]() |
| 大下邦弘「玻璃このとら」 OSHITA Kunihiro “Crystal tiger” |
![]() |
| 鈴木ひょっとこ「針先から白虎」 SUZUKI Hyottoko “White tiger from needle” |
【 白白庵オンラインショップ 期間限定 】 PAKUPAKUAN.SHOP For a limited time ※会期終了しました。This exhibition was finished.
![]() |
![]() |
![]() |
![]() |
![]() |
![]() |
![]() |
![]() |
| 伊豆野一政 IZUNO Kazumasa |
大下 邦弘 OSHITA Kunihiro |
金田 花季 KANEDA Hanaki |
かのうたかお KANO Takao |
栢野 紀文 KAYANO Kibun |
小孫哲太郎 KOMAGO Tetsutaro |
鈴木ひょっとこ SUZUKI Hyottoko |
高橋由紀子 TAKAHASHI Yukiko |
![]() |
![]() |
![]() |
![]() |
![]() |
![]() |
![]() |
![]() |
| 髙橋 良 TAKAHASHI Ryo |
田川亞希 TAGAWA Aki |
田中 英一 TANAKA Eiichi |
星川あすか HOSHIKAWA Asuka |
前川 多仁 MAEKAWA Kazuhito |
山口 由次 YAMAGUCHI Yuji |
行 千草 YUKI Chigusa |
吉田 延泰 YOSHIDA Nobuyasu |
![]() |
![]() |
![]() |
| 干支物「虎」作品一覧 Zodiac "Tiger" works | 酒盃 作品一覧 Sake cups collection | 茶盌 作品一覧 Tea bowls collection |
白白庵オンラインショップでは上記作品他にもより多くの作品を掲載しております 【期間限定】厄除・迎春 特別祈念 「大縁起物展」 2021-2022 |
and more PAKUPAKUAN.SHOP Greeting the New Year special exhibition "Great exhibition of lucky charm" 2021-2022 |